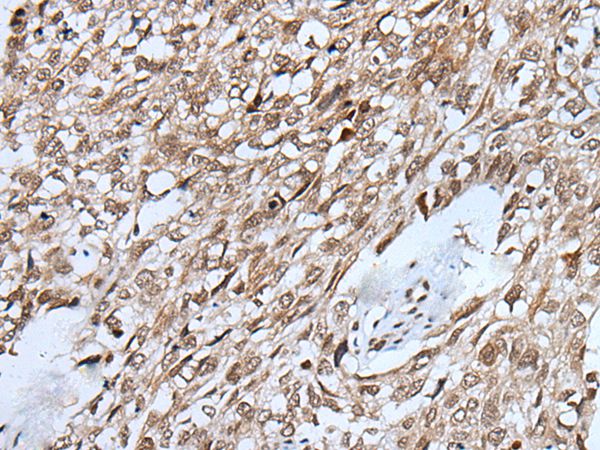

Immunohistochemical staining of human testis shows strong nuclear positivity in cells in seminiferous ducts.
Anti-VCX Antibody
HPA049357
Overview
- SupplierAtlas Antibodies
- Product NameAnti-VCX
- Delivery Days Customer4
- ApplicationsImmunoHistoChemistry
- CertificationResearch Use Only
- ClonalityPolyclonal
- ConjugateUnconjugated
- Gene ID26609
- Target nameVCX
- Target descriptionvariable charge X-linked
- Target synonymsvariable charge protein on X with ten repeats; variable charge X-linked protein 1; variable charge, X chromosome; variably charged protein X-B1; VCX1; VCX10R; VCX-10r; VCXB1; VCX-B1
- HostRabbit
- IsotypeIgG
- Protein IDQ9H320
- Protein NameVariable charge X-linked protein 1
- Scientific DescriptionRecombinant Protein Epitope Signature Tag (PrEST) antigen sequence
- Storage Instruction-20°C,2°C to 8°C
- UNSPSC12352203